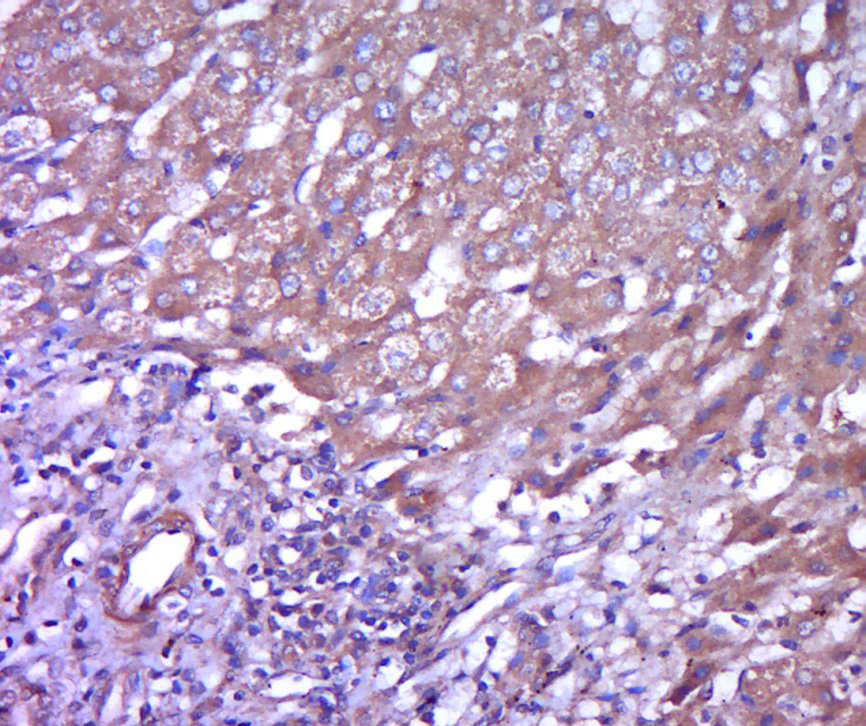

DC-SIGN Rabbit Polyclonal Antibody
Catalog# ER1907-23
DC-SIGN Rabbit Polyclonal Antibody
Application
-
WB
-
IHC-P
-
IF-Tissue
-
FC
Reactivity
-
Human